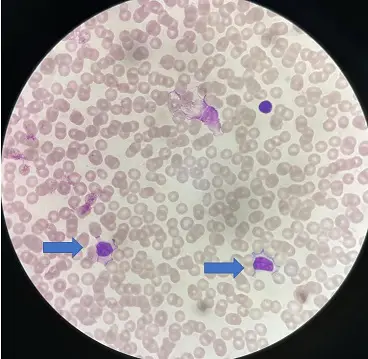
圖片描述

114年:醫學四(1)
2歲男童發燒5天伴隨全身性瘀點(petechiae)而住院,同時有鼻塞及雙眼眼皮浮腫。身體診察發現頸部淋巴結腫大、扁桃腺有滲出物。抽血檢查:Hb 10 g/dL、WBC 18800/μL、atypical lymphocyte 16%、platelet 20000/μL,GOT 194 IU/L、GPT 109 IU/L、CRP 0.5 mg/dL,EB VCA IgM>160.0 U/mL;血液塗片染色如圖所示。有關此疾病的敘述,下列何者最不適當?
A最有可能為Epstein-Barr virus感染
B圖中血液塗片中箭頭所指為非典型淋巴球(atypical lymphocyte)
C因為血小板低下症狀嚴重,應儘快使用抗病毒藥物治療
D短期皮質類固醇治療,可能有助於此病症的特定併發症
詳細解析
本題觀念:
小兒初次感染 Epstein-Barr virus(EBV)常表現為 infectious mononucleosis(IM)。典型症狀為發燒、咽喉炎伴扁桃腺滲出、頸部淋巴結腫大、肝轉胺酶上升與血液塗片出現 atypical lymphocytes。併發免疫性血小板低下(ITP)時可見瘀點,嚴重者需短期類固醇或 IVIG;抗病毒藥物對臨床病程並無助益。
影像分析:
血液抹片(Wright-Giemsa 染色,油鏡)可見:
• 多數紅血球大小均勻,排列散在
• 藍色箭頭所指細胞體積明顯大於周圍淋巴球,細胞質寬廣而深藍,周邊可見變形貼附紅血球的「指狀突起」,核膜不規則且染色質較鬆散—這正是 EBV IM 中典型的 reactive (atypical) lymphocyte
• 且未見早幼粒球過度增加或爆細胞堆積,排除急性白血病
影像支持「EBV 引起之感染性單核球增多症」。
選項分析
-
選項A
EBV VCA-IgM 高度陽性、血片見 atypical lymphocyte,加上臨床三聯症(發燒、咽喉炎、淋巴結腫大)與輕度肝功能異常,最符合 EBV 感染,敘述正確。 -
選項B
圖示細胞符合 reactive lymphocyte 特徵(細胞質擴大、邊緣貼附紅血球、核不規則),箭頭確為 atypical lymph
...(解析預覽)...
![醫師[2] - 病毒感染 - AI 圖文解析預覽](/_next/image?url=https%3A%2F%2Fbgvxfcrmbdvefjhuvrmt.supabase.co%2Fstorage%2Fv1%2Fobject%2Fpublic%2Fvisual-explanations%2F179%2F841_t529f6c51.webp&w=1920&q=75)
升級 VIP 解鎖圖文解析